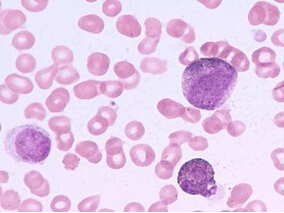
诱导化疗失败的AML患儿干细胞移植长期结局好
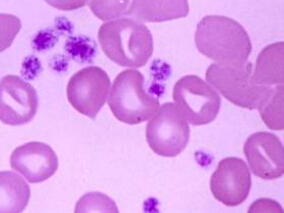
吗替麦考酚酯治疗重症免疫性血小板减少症的有效性

-
心血管事件高危女性采取地中海饮食可降低乳腺癌风险
环球医学资讯
2015年12月17日
点击量:335
1小时条评论一些观察性研究显示地中海饮食或许能够降低乳腺癌风险。2015年12月,发表在《JAMA Intern Med》上的一项研究显示,有特级初榨橄榄油的地中海饮食方式对乳腺癌一级预防有获益。 nbsp; 重要性:目前,乳腺癌已成为女性肿瘤负担的主要原因,自2008年以来,其全球发生...
-
多发性骨髓瘤患者自体HSCT后使用免疫球蛋白能否降低…
环球医学资讯
2015年12月17日
点击量:382
1小时条评论2015年10月,发表在《Transpl Infect Dis》的一项回顾性分析表明,进行自体造血干细胞移植的多发性骨髓瘤受者,移植后感染率并不会因预防性应用IVIG而不同。 背景:虽然静脉注射免疫球蛋白(IVIG)未被常规推荐,很多中心仍然在造血干细胞移植后(HSCT)使用IVIG。 ...
-
肿瘤患者索拉非尼治疗相关死亡风险有多高?
环球医学资讯
2015年12月16日
点击量:526
1小时条评论目前关于索拉非尼发生致死性不良事件的数据较少。2015年12月,发表在《International Journal of Clinical Pharmacy》上的一项研究显示,索拉非尼出现致死性不良事件(FAE)风险显著较高,但低于多靶点抗酪氨酸激酶抑制剂。 nbsp; 背景:索拉非尼是一种用于治疗多...
-
成人肿瘤患者非肿瘤药物数目多导致潜在DDI风险高
环球医学资讯
2015年12月16日
点击量:1090
1小时条评论肿瘤患者有较高的药物ndash;药物相互作用(DDI)风险。2015年12月,发表在《International Journal of Clinical Pharmacy》的一项研究显示,较多数目的非抗肿瘤药物为与DDI相关的主要危险因素。 nbsp; 背景:肿瘤患者有药物ndash;药物相互作用的高风险(DDI),这...
-
有乳腺癌病史的RA患者:TNF抑制剂治疗对乳腺癌复发…
环球医学资讯
2015年12月15日
点击量:349
1小时条评论2015年12月,发表在《Ann Rheum Dis》的一项研究表明,具有乳腺癌病史的RA患者中,与其他RA治疗方式的患者相比,开始TNFi治疗的患者没有经历更严重的乳腺癌复发。 目的:旨在调查肿瘤坏死因子抑制剂(TNFi)治疗伴有乳腺癌病史的类风湿关节炎(RA)患者乳腺癌复发风...
-
ACNU与钆双胺共同给药的实时磁共振成像用于脑肿瘤监…
环球医学资讯
2015年12月15日
点击量:276
1小时条评论增强对流输注(CED)已被开发作为一种治疗脑肿瘤的有效药物输送策略。理想中通过CED的药物灌注组织分布的直接显像将确保治疗药物向脑肿瘤成功输送,同时使正常脑组织的暴露最小化。既往在啮齿动物颅内移植瘤模型中的研究显示,通过CED输送盐酸尼莫司汀(ACNU)具有抗...
-
诱导化疗失败的AML患儿干细胞移植长期结局好
环球医学资讯
2015年12月09日
点击量:242
1小时条评论很大比例的急性髓性白血病(AML)儿童因对化疗原发性抵抗导致诱导失败。2015年11月,发表在《British Journal of Haematology》上的一项长期随访的研究结果发现,进行移植术的患儿长期结局很乐观。 nbsp; 摘要:儿童急性髓性白血病(AML)因对化疗原发性抵抗导致诱...
-
惰性NHL患者硼替佐米联合R-CHOP有效
环球医学资讯
2015年12月09日
点击量:284
1小时条评论I期试验证实含硼替佐米的联合治疗经用于非霍奇金淋巴瘤(NHL)有效。2015年11月,发表在《British Journal of Haematology》的II期试验结果显示,惰性NHL患者进行硼替佐米联合R-CHOP治疗是有效的。 nbsp; 摘要:尽管外周神经病变限制了其剂量强度,但是含硼替佐米...
-
吗替麦考酚酯治疗重症免疫性血小板减少症的有效性
环球医学资讯
2015年12月09日
点击量:330
1小时条评论重症免疫性血小板减少性紫癜(ITP)二线治疗选择比较多。2015年11月,发表在《British Journal of Haematology》上的一项研究显示,吗替麦考酚酯(MMF)是具有一定治疗效果的节制激素免疫抑制疗法。 nbsp; 重症免疫性血小板减少性紫癜(ITP)目前是临床的一大挑战。...
-
中性粒细胞减少患者进行粒细胞输注治疗是否有效?
环球医学资讯
2015年12月09日
点击量:308
1小时条评论高剂量粒细胞输注疗法已经在临床上使用多年。但2015年10月,发表在《Blood》上的一项多中心随机对照试验显示,对于可能感染的中性粒细胞减少症患者,粒细胞输注法对于主要结局整体没有影响。 nbsp; 摘要:高剂量粒细胞输注疗法已经问世20年,但其临床疗效尚未得到...

会员登录

